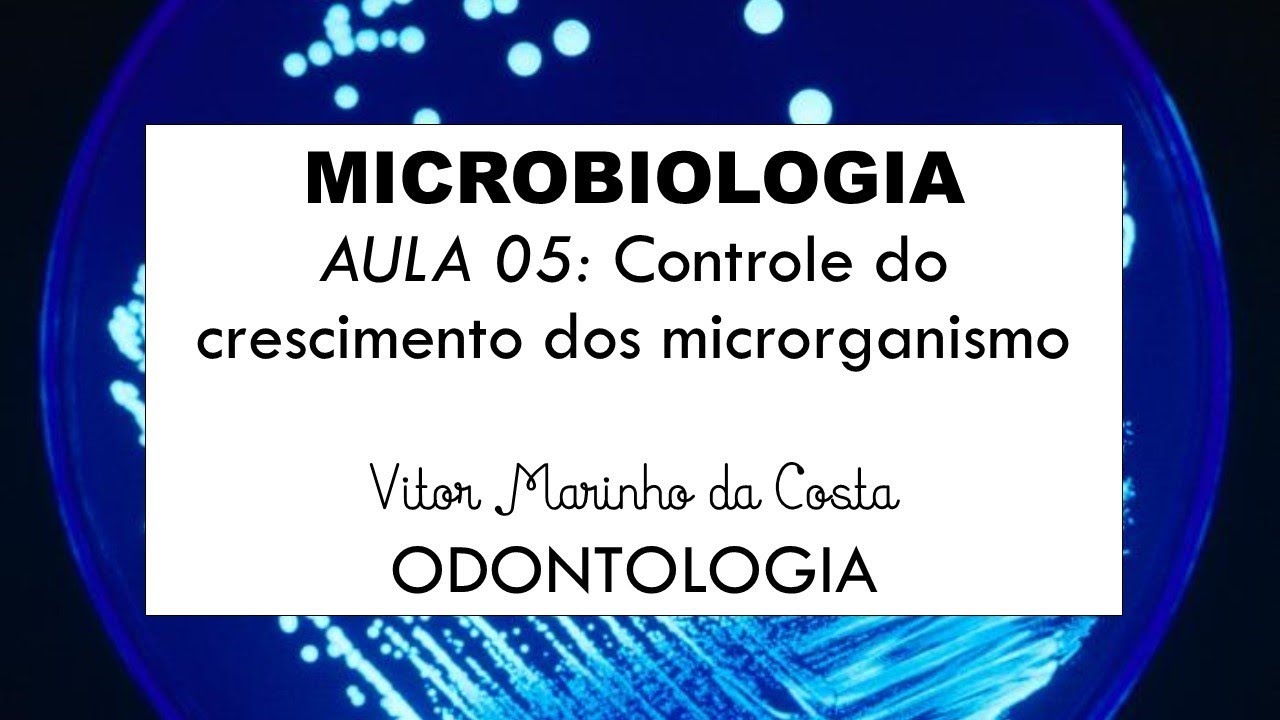
AULA 05   Controle do crescimento dos microrganismos PARTE I

[Música] o [Música] olá essa é a 4ª aula da disciplina de microbiologia e imunologia nessa aula você vai ver o crescimento microbiano e o controle do crescimento microbiano e por que é importante se conhecer com o crescimento microbiano como que os microorganismos se proliferam e quais são os fatores é necessário para que esse crescimento ocorra isso é interessante isso é importante por alguns fatores por exemplo conhecendo quais são esses mecanismos e os fatores que favorecem o necessário para que isso ocorra a gente pode eventualmente controlar o crescimento microbiano em que momentos no momento por exemplo
de uma a de um crescimento de microorganismos que desencadeiam doenças ou até mesmo a deteriorização de alguns alimentos ou também a gente pode usar esse conhecimento para promover o crescimento de microorganismos né em culturas pra identificar se identificar alguma infecção é o patógeno responsável por alguma infecção ou estudar com esses microorganismos se organizam estudar é é um desenvolvimento da microbiologia se deu muito aliás em função disso ou até mesmo promover microorganismos que não são é que não causam nenhum malefício ao nosso corpo é que são benéficos por exemplo os microorganismos que formam a nossa microbiota
então é extremamente importante e interessante conhecer como se dá como ocorre é como ocorre o crescimento dos microorganismos e como podemos é controlar quais são os mecanismos de controle desse crescimento tudo bem bom o que se entende por crescimento microbiano crescimento microbiano não é o crescimento do microorganismo né de um microorganismo não aumenta não é o aumento de tamanho de um microorganismo apesar de que eles aumentam o seu tamanho pode até dobrar de tamanho na maioria das vezes mas quando a gente fala de crescimento microbiano a gente está falando da proliferação desses microrganismos né como
eles se multiplicam eles se reproduzem é isso que significa crescimento microbiano tudo bem o bom dessa forma os objetivos gerais que a gente vai abordar nessa aula é conhecer os fatores físicos e químicos que interferem no crescimento e no controle do crescimento microbiano entender o processo de formação dos biofilmes e sua relação com a nossa saúde e também compreender os processos de reprodução bacteriana e suas fases de crescimento vamos lá bom os fatores de crescimento microbiano podem ser divididos em dois grandes grupos que são eles os físicos e os químicos nos físicos a gente tem
a temperatura o ph e também a pressão osmótica e nos químicos a gente pode destacar a presença de alguns elementos que são o carbono oxigênio os elementos traços fatores de crescimento orgânico nitrogênio enxofre e fósforo vamos agora é é é discutir alguns aspectos de alguns desses elementos físicos e químicos e como eles então influenciam o crescimento microbiano bom vamos olhar primeiro para a temperatura esse crescimento é de um de um certo grupo específico de microorganismos ele ele ocorre dentro de uma faixa adequada da temperatura então isso significa que existe uma temperatura mínima para que o
crescimento ocorra sendo que abaixo dessa temperatura o crescimento a proliferação está inibida tem uma temperatura ótima que é a mais adequada onde as reações enzimáticas né que estão ocorrendo elas estão na uma velocidade extremamente elevada e tem também no outro extremo a temperatura máxima acima da qual também não ocorre o crescimento desse grupo específico de microorganismo então cada tipo de microrganismo tem uma faixa de temperatura é adequada para o crescimento daquele microorganismo tudo bem bom se nós observarmos alguns grupos desses microrganismos quisermos dividi-los em classes térmicas a gente vai com é enxergar o seguinte panorama
aqui então nós temos a maioria dos micro organismos eles fazem parte desse grupo aqui ó que são os meus óvulos os meus off luz eles se reproduzem a uma temperatura temperatura ideal é muito próxima da nossa temperatura corporal e eles são a grande maioria dos micro organismos depois nós temos alguns extremos nós temos o zíper termófilos que se reproduzem a temperaturas altas não é o ideal mas eles conseguem também se reproduzir a temperaturas que chegam acima do ponto de ebulição e no outro extremo os psicotrópicos que se reproduzem a temperaturas muito baixas né a média
é o ideal é em torno de 12 3 graus mas eles também conseguem se reproduzir a temperaturas bem abaixo de zero tem os intermediários que são os psicotrópicos e também os termómetros aqui algum exemplo só de microorganismos e hipertermófilas né esses microrganismos então aqui a gente tem uma foto micrografia de uma lâmina que foi imersa nessa fonte que é uma fonte que tem o seu ponto é a sua temperatura também acima do ponto de ebulição ela chega a a ferver né a água dessa dessa fonte e mesmo assim se encontra aqui uma colônia de microorganismos
que se proliferam a essa temperatura extremamente elevado e aqui um exemplo de vários microorganismos psicrófilos que que habitam a antártida e aqui a gente tem o exemplo desse lago onde tem mais ou menos uma camada de cinco metros de gelo e abaixo dela a camada de gelo com a temperatura extremamente baixa a gente consegue encontrar é colônias de diversos tipos de microorganismos é tanto procure outros como eucariotos inclusive né e então são exemplos extrema interessantes de extremos de de microorganismos que se proliferam a temperaturas é bem extremas né e aqui os teimosos os terremotos eles
se vocês lembrarem do gráfico que a gente mostrou que eu mostrei a eles se proliferam a temperatura um pouco acima da nossa temperatura corporal mas é um grupo de microrganismos bactérias bastante importante em algumas situações como por exemplo na compostagem porque é o processo de compostagem e atingir uma temperatura alta relativamente rápido e permite que as bactérias ali presentes se proliferem também uma quantidade grande rapidamente e elas então participam do processo de degradação do material orgânico dessa compostagem então isso é muito benéfica extremamente favorável essa temperatura presente no na compostagem orgânica continuando ainda abordando um
pouquinho da temperatura é vocês já conseguem observando isso que a gente conversou a imaginar que um dos mecanismos de controle do crescimento microbiano pode ser o controle da temperatura do ambiente é da temperatura do ambiente em que eles se encontram e o mais comum é que faz parte das nossas vidas hoje cotidianamente é a o uso do refrigerador por que por que ele diminui a temperatura a ponto de impedir ou diminuir na verdade essa é a palavra mais adequada diminuir o crescimento dos microorganismos presentes nos alimentos então nós temos aqui uma temperatura mais ou menos
em torno de 0 a 15 grau a 7 graus que a temperatura do refrigerador a parte debaixo dele a gente tem 13 cimento muito lento das bactérias né que deterioram os alimentos e lá no congelador é onde há um pouquinho mais frio a gente pode ter quase que nenhum crescimento significativo nas temperaturas abaixo de zero um outro fator físico muito interessante muito importante é a pressão osmótica como que se dá esse fator como que a pressão osmótica pode então participar do crescimento microbiano vejam só se uma célula de uma bactéria se encontra em uma solução
em um meio isotônico o que acontece aos moss e entre essas ela citou a acita plasma dessa célula e esse meio que ela se encontra é faz com que a mesma quantidade de água que entra nesta bactéria parece a mesma quantidade que sai já que o meio é isotônico e não você não vai aumentar a quantidade de líquido dentro dessa célula e não em diminuir ela vai se manter estável enquanto que se você se essa célula se encontra em uma solução onde a concentração dos o luto está extremamente alto ou seja uma solução e personifica
por osmose essa célula vai perder líquido por esse meio né isso vai fazer com que diminua muito a concentração de água diminuindo muito as reações enzimáticas necessárias pela proliferação celular chegando ao ponto até da membrana plasmática se separar da parede celular isso inviabiliza então a divisão ea proliferação bacteriana aqui também vocês já devem imaginar que abre é o brincar com a pressão osmótica jogar modificar a pressão osmótica de uma solução ou de um alimento pode sim é desfavorecer o crescimento microbiano ea gente também faz isso comumente por exemplo quando a gente faz um doce uma
compota uma geléia agente adiciona uma quantidade de açúcar grande naquele o ambiente que faz com que o meio fica e fique e personne kuhn e eventuais bactérias que causariam a degradação do alimento da fruta enfim ela é ela perde líquido pro meio e isotônico e ela não diminui ou fica é ausente a sua proliferação né as carnes salgadas é quando você salva uma carne né as carnes fiscais e cachucha que enfim eles também é buscam acionar esse esse processo esse mecanismo né de alterar a pressão osmótica da região onde se encontra o microorganismo pra n
biodiesel no ir à proliferação do mesmo um outro fator é o ph da região onde se encontra o micro organismo aqui é importante destacar o seguinte ó que o ph ótimo para o crescimento de qualquer organismo é uma medida apenas do meio extra celular porque o ph entra celular deve permanecer relativamente próximo à neutralidade não deve se alterar então o intracelular permanece relativamente constante e próximo a neutralidade a fim de evitar a destruição das macro moléculas celulares necessárias para essa proliferação tudo bem então sempre que a gente disser ou se a gente é tivesse é
se referindo a alterações do ph nós estamos restringindo nos referindo a essas alterações do meio extra celular nesse sentido a gente tem é também uma divisão uma relação de microorganismo que é a maioria deles que se prolifera em um ph neutro né e em torno de 5 e 6 e 8 que é muito próximo do nosso ph corporal também usasse dof luz que se proliferam em ph mais baixos né mais astutos e usar o carlinhos alkali usar o qualify lico que se proliferam em um ambiente com um ph mais alcalino ou seja mais elevado certo
aqui alguns exemplos de alimentos de substâncias que e os ph é referentes né então a gente tem aqui o nosso ph que é mais ou menos em torno de 7 meio né e aqui olha a gente tem o ph vai diminuindo ou seja vai se tornando mais ácido então nós temos aqui a presença de algumas frutas de refrigerante né é muito difícil você ver um refrigerante se estragar né os microrganismos dificilmente consegue conseguem se proliferar dentro de um copo de coca cola porque é extremamente ácido e uma quantidade pequena de microorganismos é é acham adequada
sph e extremamente astro para se proliferar né então quanto mais próximo aqui do ph normal mais fácil de se degradar ou desse micro organismo se proliferar mas isso não vale só pus me para os micro organismos que estão nos alimentos é do nosso corpo também funciona assim o nosso ph não é constante não é o mesmo nosso corpo inteiro em algumas regiões ele é um pouquinho diferente né então nós temos um ph mais ácido no estômago é na boca a no trato urinário e no trato é genital e isso faz com que a algumas colônias
se desenvolvam colônias essas que preferem essa faixa de ph um pouco mais ácida e quando a gente tem eventualmente a alteração desse ph por exemplo isso ocorre é é relativamente comum que a própria microbiota daquela região estabeleça o ph então se essa microbiota por algum motivo qualquer e se desregula existe um crescimento maior de um micro organismo dela do que de outro enfim isso pode alterar esse ph local permitindo eventualmente o crescimento de patógenos é de microorganismos patogênicos que não se desenvolveriam se o ph tivesse sido mantido adequado pra que ela a região como como
comentei com vocês algumas regiões é o ph é mais ácido e algumas regiões o nosso ph do nosso corpo nos ph é um pouquinho mais básico bom e os fatores químicos nós temos diversos fatores químicos vamos destacar que alguns deles né apesar de que a água é o grande é o mais importante deles a gente também tem alguns outros elementos o carbono sem dúvida nenhuma porque ele é responsável pela formação do esqueleto é da estrutura de toda matéria viva nitrogênio enxofre e fósforo participam ainda da ciência de materiais biológicos celulares os elementos traços eles são
usados em quantidade pequena na maioria das vezes nem pra promover a função de algumas enzimas e alguns exemplos desses elementos traços desses elementos traço é o ferro o cobre o zinco e mais adiante a gente vai ver que uma a participação do ferro no controle do crescimento microbiano é muito interessante isso e alguns fatores de crescimento orgânicos que são necessários para o funcionamento de enzimas celulares alguns exemplos são as vitaminas e os aminoácidos bom dos fatores químicos vamos dar uma olhadinha no oxigênio como é que ele pode participar desse crescimento microbiano e eu já adianto
para vocês que vocês devem imaginar que é a presença do micro dome do oxigênio que sempre favorece o crescimento microbiano e na verdade não é assim nós temos alguns microorganismos que s tronic que preferem é que se proliferam uma com uma concentração na presença de oxigênio alguns preferem uma concentração mais alta outros preferem uma concentração mais baixa e outros preferem a ausência do oxigênio pra se proliferarem tudo bem e para alguns poucos isso é indiferente ele se prolifera quase que em qualquer uma dessas situações vamos ver quem são esses microrganismos então a gente pode chamar
os aeróbios obra tórios aqueles onde somente ocorre o crescimento na presença do oxigênio e aqui nessa figura a gente pode observar que o crescimento microbiano está próximo neste tubo a região onde se encontra o a ou seja o oxigênio nós temos também os aeróbios facultativos que como eu comentei com vocês agora a pouco eles mais ou menos são indiferentes a essa concentração mas eles preferem a a concentração um pouco mais elevada de oxigênio nós temos os anaeróbicos obrigatórias ou seja apenas crescem na ausência do oxigênio que é o que a gente vê aqui ele se
distancia o máximo possível da presença do oxigênio pra poder a se proliferar os anaeróbicos aero tolerantes apenas crescimento anaeróbio o crescimento continua na presença de oxigênio né então eles toleram o creci o oxigênio e os micro a herói filos crescimento somente aeróbio e oxigênio requerida de baixa concentração então eles estão lá não é que para eles é diferente eles querem um oxigênio é que naqueles que querem eles se proliferam na presença de oxigênio só que numa concentração é um pouco mais baixa do que o oxigênio presente é no ar atmosférico tudo bem meu filme a
gente já falou isso disso algumas vezes nessa disciplina e novamente ele aparece é o que é o biofilme é uma comunidade microbiana que geralmente se forma como uma camada limosos em uma superfície quais são as vantagens de se exibir o filme porque é vantajoso para o crescimento microbiano esse tipo de organização em colônias nem com diversos microorganismos diferença estabelecendo formando essa coluna é que a gente chama de biofilme bom algumas são vantagens umas coisas só vão por exemplo a proteção ao desenvolvimento porque é essa essa organização de vários microorganismos pode fazer com que os microorganismo
os microrganismos mais internos localizados mais internamente nessa nessa colônia neste biofilme eles fim eles podem ficar invisíveis ao nosso sistema imunológico por exemplo ou eles podem ser protegidos de condições extremas que a eles não é interessante uma temperatura um pouco mais elevada uma concentração de oxigênio diferente o ph ou seja esses fatores que nós acabamos de comentar com vocês nem favorecimento das relações simbióticas um exemplo disso é a troca de nutrientes entre eles então eles podem se favorecer mútuamente é propiciando um crescimento maior e mais adequado e sobrevivência em ambientes hostis né que vai está
muito relacionada aqui a essa proteção o desenvolvimento porque é exatamente isso esses microrganismos mais externos podem eventualmente proteger os localizados mais internamente de alguns fatores é não tão adequados próprio seu crescimento desenvolvimento e manutenção bom como os biofilmes se formam né antes de mais nada é necessário que um micro organismo uma bactéria por exemplo se é adere a uma superfície e depois outros micro-organismos bom é é aderir ao próprio micro a própria bactéria ou a outras regiões dessa superfície até que isso é continuar acontecendo progressivamente e se estabeleça a colônia é o biofilme isso pode
ser formado de forma linear uma camada linear desses microrganismos o que não é muito vantajoso a gente já vai entender porque eles podem se formar e em em forma de pilares porque é interessante esse essa configuração em forma de pilares porque os nutrientes vão ter acesso mais facilmente a todos os microorganismos né que vão passar por entre esses pilares e também a substância é os resíduos metabólicos desses micro organismos vão ser mais facilmente eliminados e é levados é pra lá regiões mais distantes né isso isso pode até ser considerado como um sistema circulatório extremamente primitivo
né dessa organização dos biofilmes a gente tem alguns que estão relacionados a doenças é que a formação do biofilme não é muito vantajoso para a nossa saúde quais são os exemplos clássicos disso por exemplo a placa dentária é o tartu é um biofilme que se forma na nossa superfície do dente que não é muito vantajoso porque propicia cárie e algumas outras é disfunções locais né temos também aqui a saburra lingual que também em excesso e dependendo da situação ela pode ter uma composição da sua microbiota que também não é muito vantajoso para o nosso organismo
biofilmes que podem se formar na superfície interna de cateter é isso é muito comum mas a grande maioria das infecções relacionadas ao cuidado da saúde estão ligadas ao desenvolvimento de biofilme sim cateter ou não necessariamente o desenvolvimento de um biofilme no nosso corpo mas por exemplo na lente de contato a gente até tem algumas proteções naturais que a gente já vai ver né a nossa conjuntiva da lágrima enfim que nos protege dessa dessa formação de biofilme nos nossos olhos mas na lente de contato que vai de 1 de encontro direto com essa superfície é mucosa
pode sim ter a formação de uma de um biofilme que pode desencadear aí por exemplo uma conjuntivite né mas temos também os fios biofilmes colaboradores né que são benéficos para a nossa saúde de maneira direta ou indireta e de outros animais também por exemplo no trato gastrointestinal dos ruminantes existe uma colonização é de biofilme muito é rica e é na verdade a grande responsável pela digestão dos alimentos ingeridos pelos ruminantes né então ela é extremamente benéfica e necessária para os ruminantes um outro exemplo por exemplo são os biofilmes formados na raiz de algumas plantas é
que podem ser utilizadas por a biorremediação que são por exemplo os jardins filtrantes né eles são colocados em lagos rios que estão poluídos por dejetos orgânicos né até mesmo o esgoto e tudo mais e essas bactérias então que se formam na superfície da raiz dessas plantas podem participam da degradação desses componentes orgânicos né fala é realizando a i uma biorremediação bom entendendo quais são os fatores né que contribuem para esse crescimento microbiano né questão é que devem estar adequados para o crescimento microbiano foi entender como como ocorre a divisão da da bactéria no caso bom
a divisão bacteriana ocorre por uma ficção minaria ou seja uma divisão da célula bacteriana em duas partes como que isso ocorre inicialmente a célula se alonga e o dna é replicado bom posteriormente aparelho celular ea membrana plasmática inicia uma constrição geralmente na região central e aí sim essas paredes intermediárias se formam separando completamente né fazendo realmente a fissão bacteriana e as duas células se separam e essas células depois conseqüente consecutivamente vão se dividir em outras duas e assim por diante permitindo o crescimento exponencial dessa bactéria tudo bem bom esse tempo tempo que esse processo demora
que essa disse que essa missão binária demora se chama tempo de geração esse tempo de geração depende de fatores nutricionais fatores genéticos e também da temperatura da região onde essa bactéria se encontra bom a gente olhou para o crescimento de uma bactéria individualmente agora se a gente olha para o crescimento de uma população bacteriana a gente consegue também identificar algumas fases de crescimento mas são fases de crescimento da população bacteriana que fazem são essas a gente tem a fase lag onde ocorre uma pouca ou ausência de divisão celular mas não significa que nada esteja acontecendo
essas células se encontra em estado de latência de latência mais intensa atividade metabólica ela está se preparando pra realizar a aferição binária né a divisão na fase log as células iniciam seu processo de divisão é o período de maior atividade metabólica é onde as células se multiplicam com alta velocidade ela se proliferam rapidamente claro que considerando as condições fornecidas pelo meio né se todos aqueles fatores que a gente conversou até agora estão adequados e se a temperatura adequada os fatores nutricionais e tudo bem bom porém nessa fase os microrganismos são extremamente sensíveis às mudanças ambientais
então é uma fase onde se você quer encerrar é é é bloquear o crescimento microbiano é uma fase interessante de colocar algum agente é antigo como exemplo antibióticos radiações se você quer que esse que essa a essa população se desenvolva é um momento de cuidado porque existe a fragilidade dessas bactérias depois tem uma fase estacionária onde tem uma diminuição da atividade metabólica das células e o número de morte celular é igual ao número de células novas porque a gente não pode esquecer que essas células têm um tempo de vida então as células vão se proliferando
né vão nascendo né e ela tem um tempo de vida e morre então nessa fase estacionária a mesma quantidade de células novas é a mesma quantidade de células que morrem então a quantidade total tamanho 10 idc dessa colônia permanece constante ea última fase é a fase de morte celular onde o número de células mortas excede o número de células novas ea gente já pode imaginar o que acontece é uma diminuição progressiva da colônia a bacteriana a gente pode observar essas fases neste gráfico aqui né que tem aqui o blog numérico debate das bactérias também a
gente tem a fase lag onde tem uma atividade metabólica presente está se preparando para fazer log não tem a maior atividade metabólica e maior crescimento um crescimento exponencial a fase estacionária número de mortos e igual número de bactérias novas e depois a fase de morte um declínio onde um número de mortes e sete o número de novas bactérias ok agora vamos entrar na segunda etapa da aula aqui a gente vai tratar do controle do crescimento microbiano na primeira aula eu até sinalizei pra vocês como que ocorreu o início tá dos mecanismos de controle do crescimento
microbiano as primeiras práticas de controle do crescimento microbiano era ocorreu por volta de 1800 por alguns médicos que começaram há tanto lavar as mãos antes antes de realizar os procedimentos médicos como usar alguns é a gente é anti microbianos né que controlavam o crescimento microbiano isso teve bastante sucesso mas foi um longo caminho até que a gente é conhecer se a o que a gente vai aprender o que eu vou apresentar a vocês agora essa gama enorme de possibilidades de controle do crescimento microbiano bom é como é comum a gente falar nesses termos quando falo
quando falamos de crescimento microbiano de controle do crescimento microbiano que é a esterilização o que é atualização é exatamente a um processo de remoção ou destruir ou destruição de toda a vida microbiana em um objeto a desinfecção é o processo que visa apenas a reduzir ou inibe o crescimento microbiano em alguma superfície também animada e antissepsia ou assepsia já é o processo de redução ou inibição dos microrganismos em tecidos vivos a gente não consegue esterelizar tecidos vivos né mesmo porque os tecidos dependem da presença dos microorganismos pra permanecerem vivos a gente consegue apenas realizar uma
desinfecção uma uma assepsia uma diminuição na quantidade ou na proliferação dos microorganismos bom quem são esses agentes de controle microbiana e como que eles atuam né de qualquer forma qualquer tipo de agente vai atuar basicamente de duas maneiras ou alterando a permeabilidade da membrana ou causando danos às proteínas e aos ácidos nucleicos o que é inviável pra vida e clube ana e para a sua proliferação bom desses agentes microbianos nós temos dois grupos que são os métodos físicos e os métodos químicos dos métodos físicos um dos principais é o calor que a gente até já
comentou agora há pouco aqui eu vou mostrar alguns quadros algumas tabelas pra vocês mas não se preocupem eu vou explorar parte dessas tabelas depois com o tempo vocês olham elas também estão no material de apoio para vocês depois vocês dão uma olhada mais minuciosa nas informações que vocês acharem necessário mas aqui eu tenho uma tabela onde ela ela morta ela organiza os métodos que utilizam o calor como mecanismo de controle microbiana então nós temos o calor úmido a pasteurização e o calor seco a maioria deles vai causar desnaturação das proteínas que são muito utilizados tanto
na nossa vida cotidiana como em ambientes hospitalares cirúrgicos né e na indústria é alimentícia temos também a filtração aqui é mecanicamente separada os microorganismos de algum fluído isso é muito difícil é muito eficaz pode levar até uma esterilização de alguma substância eo frio que nós também já comentamos agora pouco é que a refrigeração ela diminui as reações enzimáticas das bactérias é diminuindo então só só metabolismo só proliferação né temos alta pressão a descer a dessecação né que é a tirar a água da bactéria já falamos disso também a pressão osmótica já como já mencionamos como
podemos usar a pressão aos módica para controlar o crescimento desse micro organismo e também a radiação que causa alterações na estrutura genética dos microorganismos bom dos métodos químicos nós temos os desinfetantes mas a maioria dos métodos químicos não promove a estrela ização né promove apenas a diminuição da concentração desses microorganismos ou da sua proliferação nós temos uma quantidade enorme o nome de agentes químicos que podem é participar desse controle microbiano eu vou estar cá alguns poucos aqui pra vocês que são mais utilizados no nosso dia a dia por exemplo o iodo que inibe a função
das proteínas e um forte agente oxidante principalmente para aquelas é proteína se una para aquelas bactérias que tem crescimento anaeróbia e também o cloro que quando em contato com a água se transforma em um ácido que altera o ph e também além disso é é altera alguns outros componentes celulares que seriam necessários para essa proliferação celular que teria temos metais pesados agente de superfícies a gente usa bastante esses agentes de superfície né que são detergentes alguns deles então até a presença em alguns sabonetes hoje está muito comum e do sabonete antisséptico né sabonete que diminui
a concentração de bactérias e tem até uma discussão se isso é adequado não é vantajoso ou não em que situação deve ser usado podemos conversar isso depois nos nossos fóruns eventualmente e conservantes químicos para alimentos são muito utilizados são amplamente utilizados pela indústria alimentícia eles diminuem então fortemente a proliferação dos microorganismos mas também aqui cabe levantar uma discussão que é nome que é que é que a gente pode é tentar debaterá e apurar o quão benéfico isso é para o nosso organismo é a presença de tantos componentes químicos é para manter aí os alimentos é
menos perecíveis temos também a esterilização química e pela oxigenação e outras formas de oxigênio que também combatem o crescimento de bactérias anaeróbias muito bem é isso que eu tinha pra vou conversar com você nessa aula a gente se vê na próxima [Música] [Música] [Música]